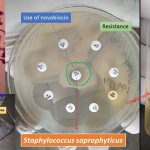
Novobiocin Susceptibility Test- Introduction, Principle, Procedure, Result Interpretation and Uses

Tag: Novobiocin Susceptibility Test
Novobiocin Susceptibility Test: Introduction, Principle, Procedure, Result Interpretation and Keynotes
 Introduction of Novobiocin Susceptibility Test Novobiocin Susceptibility Test is applied to...
Introduction of Novobiocin Susceptibility Test Novobiocin Susceptibility Test is applied to...
Novobiocin Susceptibility Test: Introduction, Principle, Procedure, Result Interpretation and Uses
Introduction of Novobiocin Susceptibility Test In Novobiocin Susceptibility Test, the...
Introduction of Novobiocin Susceptibility Test In Novobiocin Susceptibility Test, the...
